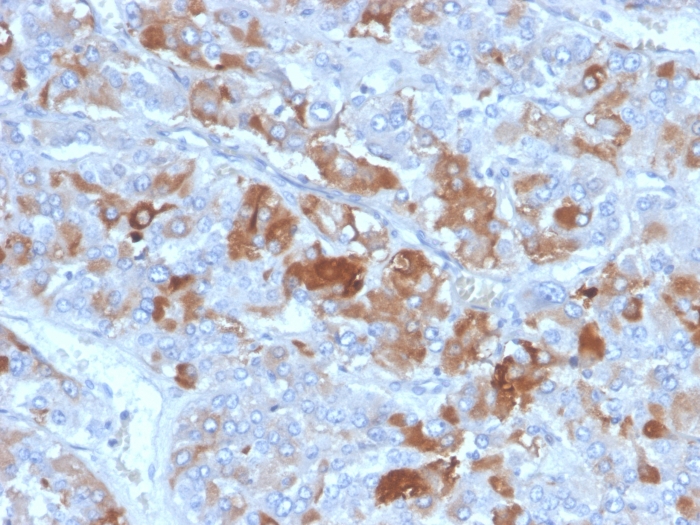

Western Blot Analysis of human tissue lysate using Clusterin / APOJ Mouse Monoclonal Antibody (CLU/4731).
Formalin-fixed, paraffin-embedded human adrenal gland stained with Clusterin / APOJ Mouse Monoclonal Antibody (CLU/4731).

Analysis of Protein Array containing more than 19,000 full-length human proteins using Clusterin / APOJ Mouse Monoclonal Antibody (CLU/4731). Z- and S- Score: The Z-score represents the strength of a signal that a monoclonal antibody (MAb) (in combination with a fluorescently-tagged anti-IgG secondary antibody) produces when binding to a particular protein on the HuProtTM array. Z-scores are described in units of standard deviations (SD's) above the mean value of all signals generated on that array. If targets on HuProtTM are arranged in descending order of the Z-score, the S-score is the difference (also in units of SD's) between the Z-score. S-score therefore represents the relative target specificity of a MAb to its intended target. A MAb is considered to specific to its intended target, if the MAb has an S-score of at least 2.5. For example, if a MAb binds to protein X with a Z-score of 43 and to protein Y with a Z-score of 14, then the S-score for the binding of that MAb to protein X is equal to 29.
Clusterin, also designated complement lysis inhibitor (CLI), apolipoprotein J (APOJ), sulfated glycoprotein 2 (SGP2), SP40 and testosterone-repressed prostate message 2 (TRPM2), is a secretory, heterodimeric glycoprotein that influences immune regulation, cell adhesion, transformation, lipid transportation, tissue remodeling, membrane recycling and cell-cell interactions. Clusterin is synthesized as a 449 amino acid polypeptide that is post-translationally cleaved at an internal bond between Arg 227 and Ser 228. Two subunits, 伪 and 尾, are associated through disulfide bonds. The 尾 subunit (also called ApoJ伪) corresponds to residues 23-227. The 伪 subunit (also called ApoJ尾) corresponds to residues 228-449. Overexpression of Clusterin appears to be more common in late stages of mammary tumor progression. Clusterin markedly influences 尾-Amyloid structure and neuritic toxicity in vivo and may influence Alzheimer s pathogenesis.
There are no reviews yet.